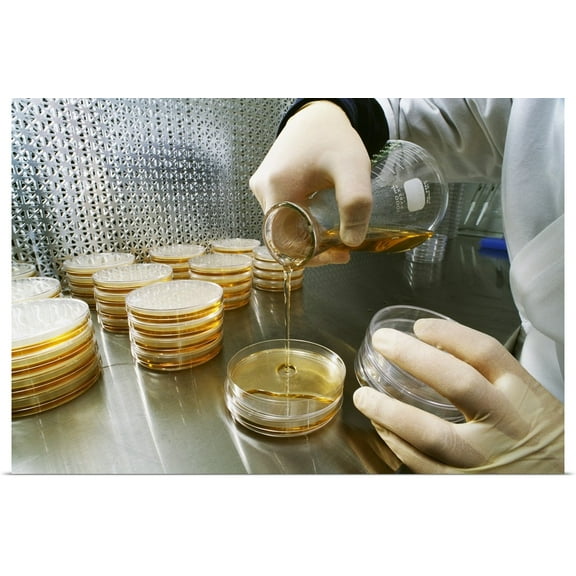
Great BIG Canvas | "A researcher in an agriculture research laboratory prepares samples" Art Print - 48x32

SafaviehShop by RoomAll BenchesAnimal DecorAppliances Parts & AccessoriesArtificial Plants and FlowersBakewareBath TowelsBathroom AccessoriesBathroom FurnitureBathroom StorageBean Bag ChairsBedroom FurnitureBenchesBetter Homes and GardensBlanketsBlinds & ShadesBohemianCandles & Home FragranceCarts & Drawer UnitsChairsChristmas DecorCloset OrganizersCoastal, Nautical, and Beach StylesCurtains & Window TreatmentsDecorative AccentsDecorative Pillows & ThrowsDining & EntertainingDorm Room EssentialsEntryway FurnitureFall DecorFarmhouseGarment Closet LaundryGlamHalloween DecorHayneedleHybrid MattressesJapandiKids StorageKids' BeddingKids' FurnitureKids' PlayroomKids' Room DecorKids' RoomsKids' StorageKids' ThemesKitchen & Dining FurnitureKitchen & Table LinensKitchen AppliancesKitchen Storage & OrganizationLaundry Storage & OrganizationLighting & Light FixturesLiving Room FurnitureMattresses & AccessoriesMid-Century ModernMinnie Mouse Home & BeddingMirrorsOffice FurnitureOffice StoragePersonalized Christmas ShopPicture FramesPostersQuiltsRugsShadow BoxesShelvingShelving StorageShop All DecorShop All Dorm Room EssentialsShop all Kitchen & DiningShop all Storage & OrganizationShower Curtains & AccessoriesSlipcoversStorage Baskets & BinsStorage ContainersStorage FurnitureTeens' BathroomTeens' BeddingTeens' FurnitureTeens' Room DecorTeens' RoomsTeens' StorageThrow BlanketsTools & GadgetsTrash CansTrends & InspirationTV Stands & Entertainment CentersUV Light Sanitizer WandsVacuums, Steamers & Floor CareWall ArtWall Decor
Sort by|
SafaviehShop by RoomAll BenchesAnimal DecorAppliances Parts & AccessoriesArtificial Plants and FlowersBakewareBath TowelsBathroom AccessoriesBathroom FurnitureBathroom StorageBean Bag ChairsBedroom FurnitureBenchesBetter Homes and GardensBlanketsBlinds & ShadesBohemianCandles & Home FragranceCarts & Drawer UnitsChairsChristmas DecorCloset OrganizersCoastal, Nautical, and Beach StylesCurtains & Window TreatmentsDecorative AccentsDecorative Pillows & ThrowsDining & EntertainingDorm Room EssentialsEntryway FurnitureFall DecorFarmhouseGarment Closet LaundryGlamHalloween DecorHayneedleHybrid MattressesJapandiKids StorageKids' BeddingKids' FurnitureKids' PlayroomKids' Room DecorKids' RoomsKids' StorageKids' ThemesKitchen & Dining FurnitureKitchen & Table LinensKitchen AppliancesKitchen Storage & OrganizationLaundry Storage & OrganizationLighting & Light FixturesLiving Room FurnitureMattresses & AccessoriesMid-Century ModernMinnie Mouse Home & BeddingMirrorsOffice FurnitureOffice StoragePersonalized Christmas ShopPicture FramesPostersQuiltsRugsShadow BoxesShelvingShelving StorageShop All DecorShop All Dorm Room EssentialsShop all Kitchen & DiningShop all Storage & OrganizationShower Curtains & AccessoriesSlipcoversStorage Baskets & BinsStorage ContainersStorage FurnitureTeens' BathroomTeens' BeddingTeens' FurnitureTeens' Room DecorTeens' RoomsTeens' StorageThrow BlanketsTools & GadgetsTrash CansTrends & InspirationTV Stands & Entertainment CentersUV Light Sanitizer WandsVacuums, Steamers & Floor CareWall ArtWall Decor
Sample Picture(29)
Uses item details. Price when purchased online
Best seller ArtToFrames 24x36 Inch Black Picture Frame, This Black MDF Poster Frame is Great for Your Art or Photos, Comes with 060 Plexi Glass (4267) From $32.00

Sponsored
From$3200
ArtToFrames 24x36 Inch Black Picture Frame, This Black MDF Poster Frame is Great for Your Art or Photos, Comes with 060 Plexi Glass (4267)
2154.6 out of 5 Stars. 215 reviews
ArtToFrames 14x14 Inch Oak Picture Frame, This Brown Wood Poster Frame is Great for Your Art or Photos, Comes with Regular Glass (4742) From $28.59

Sponsored
From$2859
ArtToFrames 14x14 Inch Oak Picture Frame, This Brown Wood Poster Frame is Great for Your Art or Photos, Comes with Regular Glass (4742)
1994.6 out of 5 Stars. 199 reviews
ArtToFrames 18" x 24" Pale Green Picture Frame, 18x24 inch Green Wood Poster Frame (WOM-4605), Pack From $45.55

Sponsored
From$4555
ArtToFrames 18" x 24" Pale Green Picture Frame, 18x24 inch Green Wood Poster Frame (WOM-4605), Pack
324.5 out of 5 Stars. 32 reviews
ArtToFrames 20" x 20" Modern Green Picture Frame, 20x20 inch Green Wood Poster Frame (WOM-4589) From $44.09

Sponsored
From$4409
ArtToFrames 20" x 20" Modern Green Picture Frame, 20x20 inch Green Wood Poster Frame (WOM-4589)
284.5 out of 5 Stars. 28 reviews
Trademark Fine Art "Sample" Canvas Art by KCDoodleArt White Matte, Black Frame From $36.44

2 options
Available in additional 2 optionsFrom$3644
Trademark Fine Art "Sample" Canvas Art by KCDoodleArt White Matte, Black Frame
Save with
Trademark Fine Art "Sample" Canvas Art by KCDoodleArt Black Matte, Black Frame $34.65

$3465
current price $34.65Trademark Fine Art "Sample" Canvas Art by KCDoodleArt Black Matte, Black Frame
Save with
Trademark Fine Art "Sample" Canvas Art by KCDoodleArt From $49.67

2 options
Available in additional 2 optionsFrom$4967
Trademark Fine Art "Sample" Canvas Art by KCDoodleArt
Save with
Trademark Fine Art "Sample" Canvas Art by KCDoodleArt White Matte, Wood Frame From $35.63

2 options
Available in additional 2 optionsFrom$3563
Trademark Fine Art "Sample" Canvas Art by KCDoodleArt White Matte, Wood Frame
Save with
Light Luxury Leather Covered Picture Frame Office Study Room Sample Room Bedroom Porch Decoration Birthday Party Gift

Light Luxury Leather Covered Picture Frame Office Study Room Sample Room Bedroom Porch Decoration Birthday Party Gift
Trademark Fine Art "Sample" Canvas Art by KCDoodleArt White Matte, Silver Frame

Trademark Fine Art "Sample" Canvas Art by KCDoodleArt White Matte, Silver Frame
Save with
ArtToFrames 13" x 13" Aqua Picture Frame, 13x13 inch Green Wood Poster Frame (WOM-5186), Pack From $27.51

Sponsored
From$2751
ArtToFrames 13" x 13" Aqua Picture Frame, 13x13 inch Green Wood Poster Frame (WOM-5186), Pack
1934.6 out of 5 Stars. 193 reviews
ArtToFrames 9" x 12" Pale Green Picture Frame, 9x12 inch Green Wood Poster Frame (WOM-4605), Pack From $28.58

Sponsored
From$2858
ArtToFrames 9" x 12" Pale Green Picture Frame, 9x12 inch Green Wood Poster Frame (WOM-4605), Pack
194.6 out of 5 Stars. 19 reviews
Trademark Fine Art "Sample" Canvas Art by KCDoodleArt Black Matte, Birch Frame Was $53.91

Trademark Fine Art "Sample" Canvas Art by KCDoodleArt Black Matte, Birch Frame
Save with
William Morris - Wallpaper Sample With Forget - Me - Nots Poster Wall Art, Modern Wall Decor For Living Room Bedroom, 24x36 UNFRAMED From $26.49

2 options
Available in additional 2 optionsFrom$2649
William Morris - Wallpaper Sample With Forget - Me - Nots Poster Wall Art, Modern Wall Decor For Living Room Bedroom, 24x36 UNFRAMED
Trademark Fine Art "Sample" Canvas Art by KCDoodleArt Black Matte, Silver Frame

Trademark Fine Art "Sample" Canvas Art by KCDoodleArt Black Matte, Silver Frame
Save with
Photographer's Edge, Photo Insert Card Sample Pack, 8 Linen w/Single Border Cards, for 4x6 Photos $22.95

$2295
current price $22.95Photographer's Edge, Photo Insert Card Sample Pack, 8 Linen w/Single Border Cards, for 4x6 Photos
Trademark Fine Art "Sample" Canvas Art by KCDoodleArt Black Matte, Wood Frame

Trademark Fine Art "Sample" Canvas Art by KCDoodleArt Black Matte, Wood Frame
Save with
European sample I-a 8x18 Black Modern Framed Museum Art Print Titled - Art Licensing Studio From $29.99

4 options
Available in additional 4 optionsFrom$2999
European sample I-a 8x18 Black Modern Framed Museum Art Print Titled - Art Licensing Studio
European Sample I-b 7x18 Black Modern Framed Museum Art Print Titled - Art Licensing Studio From $29.99

4 options
Available in additional 4 optionsFrom$2999
European Sample I-b 7x18 Black Modern Framed Museum Art Print Titled - Art Licensing Studio
Epic Graffiti 'European Sample I-d' by Art Licensing Studio Canvas Wall Art, 12" x 36" From $89.99

2 options
Available in additional 2 optionsFrom$8999
Epic Graffiti 'European Sample I-d' by Art Licensing Studio Canvas Wall Art, 12" x 36"
ArtToFrames 12" x 12" Grey Picture Frame, 12x12 inch Gray Wood Poster Frame (WOM-4594) From $31.24

Sponsored
From$3124
ArtToFrames 12" x 12" Grey Picture Frame, 12x12 inch Gray Wood Poster Frame (WOM-4594)
294.7 out of 5 Stars. 29 reviews
ArtToFrames 11" x 17" Pale Green Picture Frame, 11x17 inch Green Wood Poster Frame (WOM-4605), 2 Pack From $33.62

Sponsored
From$3362
ArtToFrames 11" x 17" Pale Green Picture Frame, 11x17 inch Green Wood Poster Frame (WOM-4605), 2 Pack
294.6 out of 5 Stars. 29 reviews
A Mother's Love is Just a Sample of God's Love for Us All- Fine Art Canvas Print (20" x 30") $105.00

$10500
current price $105.00A Mother's Love is Just a Sample of God's Love for Us All- Fine Art Canvas Print (20" x 30")
Epic Graffiti 'European Sample Ii-d' by Art Licensing Studio Canvas Wall Art, 12" x 36" From $89.99

2 options
Available in additional 2 optionsFrom$8999
Epic Graffiti 'European Sample Ii-d' by Art Licensing Studio Canvas Wall Art, 12" x 36"
1pc Personalized Watercolor Portrait Canvas Wall Art, Customizable Polyester Fiber Photo Print, Wooden Frame Artwork, Suitable for General Home Decoration From $39.02

3 options
Available in additional 3 optionsFrom$3902
1pc Personalized Watercolor Portrait Canvas Wall Art, Customizable Polyester Fiber Photo Print, Wooden Frame Artwork, Suitable for General Home Decoration
Personalized Hunting Canvas Wall Art, Live Preview, Choose Each Photo, Multiple Options

Personalized Hunting Canvas Wall Art, Live Preview, Choose Each Photo, Multiple Options
994.9 out of 5 Stars. 99 reviews
Save with
Personalized 4x6 Mini Canvas with Easel Stand by Walmart Custom in Modern Style $11.96

$1196
current price $11.96Personalized 4x6 Mini Canvas with Easel Stand by Walmart Custom in Modern Style
433.7 out of 5 Stars. 43 reviews
Save with
ArtToFrames 12" x 22" Modern Green Picture Frame, 12x22 inch Green Wood Poster Frame (WOM-4589), Pack From $49.55

Sponsored
From$4955
ArtToFrames 12" x 22" Modern Green Picture Frame, 12x22 inch Green Wood Poster Frame (WOM-4589), Pack
174.4 out of 5 Stars. 17 reviews
ArtToFrames 6" x 9" Pale Green Picture Frame, 6x9 inch Green Wood Poster Frame (WOM-4605), Pack From $34.03

Sponsored
From$3403
ArtToFrames 6" x 9" Pale Green Picture Frame, 6x9 inch Green Wood Poster Frame (WOM-4605), Pack
244.5 out of 5 Stars. 24 reviews
Other options to consider(402)
Pet Paw Print Memorial Photo Frame with Fur Keepsake Compartments, Holds 1 Pet Paw Prints Photo & 2 Fur Samples $17.98

$1798
current price $17.98Pet Paw Print Memorial Photo Frame with Fur Keepsake Compartments, Holds 1 Pet Paw Prints Photo & 2 Fur Samples
12" x 12" Personlized Acrylic Photo Print $56.98

$5698
current price $56.9812" x 12" Personlized Acrylic Photo Print
274.2 out of 5 Stars. 27 reviews
Save with
ROSENICE 2pcs Wooden Diy Sample Frame Dried Flower Display Frame For Desktop And Wall Construction $24.62

$2462
current price $24.62ROSENICE 2pcs Wooden Diy Sample Frame Dried Flower Display Frame For Desktop And Wall Construction
LEORX 2pcs Wooden DIY Sample Frame for Dried Flower Display on Desktop and Wall $31.85

$3185
current price $31.85LEORX 2pcs Wooden DIY Sample Frame for Dried Flower Display on Desktop and Wall
24x36 Size, Custom Oil Color Portrait, Custom Canvas, Canvas Print, Photo on Canvas, Photo to Canvas, Oil Color Canvas Personalized From $9.99

8 options
Available in additional 8 optionsFrom$999
24x36 Size, Custom Oil Color Portrait, Custom Canvas, Canvas Print, Photo on Canvas, Photo to Canvas, Oil Color Canvas Personalized
12 out of 5 Stars. 1 reviews
18X24, Custom Portrait, Personalized Watercolor Portrait on Stretched Canvas, Custom Canvas, Canvas Print, Canvas, Personalized Photo Canvas, Canvas Picture, Custom Watercolor, Portrait from Photo From $17.99

6 options
Available in additional 6 optionsFrom$1799
18X24, Custom Portrait, Personalized Watercolor Portrait on Stretched Canvas, Custom Canvas, Canvas Print, Canvas, Personalized Photo Canvas, Canvas Picture, Custom Watercolor, Portrait from Photo
74.4 out of 5 Stars. 7 reviews
5.25 x 5.25 Desk Photo Panel $12.96

$1296
current price $12.965.25 x 5.25 Desk Photo Panel
554.1 out of 5 Stars. 55 reviews
Save with
Yosemite Home Decor 'Serenity' 22"x18" Glass/Wood Photo in Multi-Color $52.32

$5232
current price $52.32Yosemite Home Decor 'Serenity' 22"x18" Glass/Wood Photo in Multi-Color
Walmart Custom Gallery-Wrapped 11 x 14 Framed Photo Collage Canvas Art Print $29.96

$2996
current price $29.96Walmart Custom Gallery-Wrapped 11 x 14 Framed Photo Collage Canvas Art Print
1764.2 out of 5 Stars. 176 reviews
Save with
NIAIZEK Specimen Frame 1 Piece 7.00 x 4.99 x 1.38 Inch Display Frame for Collectibles and Samples $12.23

$1223
current price $12.23NIAIZEK Specimen Frame 1 Piece 7.00 x 4.99 x 1.38 Inch Display Frame for Collectibles and Samples
Yongwei 2Pcs Glass Frame Storage Photo DIY Butterflies Sample Holder Small Display Cases

Yongwei 2Pcs Glass Frame Storage Photo DIY Butterflies Sample Holder Small Display Cases
16x14cm &18x13cm Metal Chain Hanging Glass Double Sided Photo Picture $29.99 Was $34.99

Now$2999
current price Now $29.99, Was $34.99$34.99
16x14cm &18x13cm Metal Chain Hanging Glass Double Sided Photo Picture
Best seller DSC 12x12 Gallery Wrapped Photo Canvas with Wire Hanger $23.96 $23.96/count

$2396
current price $23.96$23.96/count
DSC 12x12 Gallery Wrapped Photo Canvas with Wire Hanger
2944.3 out of 5 Stars. 294 reviews
Save with
Best seller DSC 20x60 Gallery Wrapped Photo Canvas with Wire Hanger $92.96 $92.96/count

$9296
current price $92.96$92.96/count
DSC 20x60 Gallery Wrapped Photo Canvas with Wire Hanger
684.1 out of 5 Stars. 68 reviews
Save with
Best seller DSC 8x10 Gallery Wrapped Photo Canvas with Wire Hanger $19.96

$1996
current price $19.96DSC 8x10 Gallery Wrapped Photo Canvas with Wire Hanger
10214.1 out of 5 Stars. 1021 reviews
Save with
5x7 Desktop Gallery Wrapped Canvas $14.96

$1496
current price $14.965x7 Desktop Gallery Wrapped Canvas
704.4 out of 5 Stars. 70 reviews
Save with
DSC 16x24 Gallery Wrapped Photo Canvas with Wire Hanger $46.96 $46.96/count

$4696
current price $46.96$46.96/count
DSC 16x24 Gallery Wrapped Photo Canvas with Wire Hanger
5084.3 out of 5 Stars. 508 reviews
Save with
DSC 20x24 Gallery Wrapped Photo Canvas with Wire Hanger $56.96

$5696
current price $56.96DSC 20x24 Gallery Wrapped Photo Canvas with Wire Hanger
2334.1 out of 5 Stars. 233 reviews
Save with
LEDREM 12-Piece Collage Picture Frame Set for Wall, 4x6 Photo Display with Hanging Kit, Easy-Assembly Gallery Wall Decor, Black Was $49.99

LEDREM 12-Piece Collage Picture Frame Set for Wall, 4x6 Photo Display with Hanging Kit, Easy-Assembly Gallery Wall Decor, Black
93.9 out of 5 Stars. 9 reviews
Save with
Girlsshop Hollow 5Cm Photo Frame Three-Dimensional Hollow 67810 Inch A4 Table,6 inches

Girlsshop Hollow 5Cm Photo Frame Three-Dimensional Hollow 67810 Inch A4 Table,6 inches
Best seller DSC 30x40 Gallery Wrapped Photo Canvas with Wire Hanger $92.96 $92.96/count

$9296
current price $92.96$92.96/count
DSC 30x40 Gallery Wrapped Photo Canvas with Wire Hanger
2144.4 out of 5 Stars. 214 reviews
Save with
Precious Moments You're Dino-mite Dinosaur Photo Frame, Count 1 $38.36

$3836
current price $38.36Precious Moments You're Dino-mite Dinosaur Photo Frame, Count 1
Raindrops Household Photo Frame Multi PS 1Pcs $10.76

$1076
current price $10.76Raindrops Household Photo Frame Multi PS 1Pcs
1 Box 2 Styles Mini Picture Vintage Frames White Resin Picture Frame Bulk Baroque European Oval Rectangular Embossed Photo Frame for Wall Home Wedding Decorations Jewelry Display DIY Crafts White $12.82

$1282
current price $12.821 Box 2 Styles Mini Picture Vintage Frames White Resin Picture Frame Bulk Baroque European Oval Rectangular Embossed Photo Frame for Wall Home Wedding Decorations Jewelry Display DIY Crafts White
Wall Design Pieces Plant Picture Frame 12x12" $12.02

$1202
current price $12.02Wall Design Pieces Plant Picture Frame 12x12"
Hollow 5cm photo frame three-dimensional hollow 67810 inch A4 table

Hollow 5cm photo frame three-dimensional hollow 67810 inch A4 table
Great BIG Canvas | "A researcher in an agriculture research laboratory prepares samples" Art Print - 48x32 From $58.00
2 options
Available in additional 2 optionsFrom$5800
Great BIG Canvas | "A researcher in an agriculture research laboratory prepares samples" Art Print - 48x32
Cousin DIY Paintable Framed Textured Canvas, Sideways Rainbows, 18"Length x 14"Width x 1"Height From $13.14

3 options
Available in additional 3 optionsFrom$1314
Cousin DIY Paintable Framed Textured Canvas, Sideways Rainbows, 18"Length x 14"Width x 1"Height
WHAMVOX 10Pcs Small Picture Frames Paper Made Picture Frame Assorted Color For Living Room And Bedroom $15.67 Was $17.61

Now$1567
current price Now $15.67, Was $17.61$17.61
WHAMVOX 10Pcs Small Picture Frames Paper Made Picture Frame Assorted Color For Living Room And Bedroom
Set of 12 Collage Picture Frames, 4x6, Ink Black, Wall Decor for Family Photos, Hanging Display, Assembly Required. Was $49.99

Set of 12 Collage Picture Frames, 4x6, Ink Black, Wall Decor for Family Photos, Hanging Display, Assembly Required.
314 out of 5 Stars. 31 reviews
Save with
Custom Wall Decal : Horseshoe Western Star Picture Frame Cowboy Cowgirl Home Decor Living Room Bedroom 20x20 $20.95

$2095
current price $20.95Custom Wall Decal : Horseshoe Western Star Picture Frame Cowboy Cowgirl Home Decor Living Room Bedroom 20x20
Homoyoyo Multi-Functional Desktop Picture Frame Display Stand, 1 Piece, and Stylish Photo Holder for Home and Office $11.99

$1199
current price $11.99Homoyoyo Multi-Functional Desktop Picture Frame Display Stand, 1 Piece, and Stylish Photo Holder for Home and Office
Hollow 5cm photo frame three-dimensional hollow 67810 inch A4 table

Hollow 5cm photo frame three-dimensional hollow 67810 inch A4 table
LOLIPPYY 6Pcs Micro Photo Frame MDF Assorted Color Picture Display $9.19

$919
current price $9.19LOLIPPYY 6Pcs Micro Photo Frame MDF Assorted Color Picture Display
HOMEMAXS 20 Pcs Film Cardboard Photo Frame Single Display Delicate $8.51 Was $10.68

Now$851
current price Now $8.51, Was $10.68$10.68
HOMEMAXS 20 Pcs Film Cardboard Photo Frame Single Display Delicate
Vintage 2-side Chain Hanging Glass Photo Frame Picture Holder Plant Dried Flower Holder - Black, 20x15cm B 20x15cm

Vintage 2-side Chain Hanging Glass Photo Frame Picture Holder Plant Dried Flower Holder - Black, 20x15cm B 20x15cm
Living Room Art Horseshoe Western Star Picture Frame Cowboy Cowgirl 16x16 $15.50

$1550
current price $15.50Living Room Art Horseshoe Western Star Picture Frame Cowboy Cowgirl 16x16
The Elements - Sampled Periodic Table Poster Wall Art, Modern Wall Decor For Living Room Bedroom, 12x18 UNFRAMED

The Elements - Sampled Periodic Table Poster Wall Art, Modern Wall Decor For Living Room Bedroom, 12x18 UNFRAMED
Collage Picture Frames, 4x6 Picture Frames Collage for Wall Decor, 10 Pack Photo Collage Frame for Gallery, Multi Family Picture Frame Set, Glass Front, Assembly Required, Rustic Brown

Collage Picture Frames, 4x6 Picture Frames Collage for Wall Decor, 10 Pack Photo Collage Frame for Gallery, Multi Family Picture Frame Set, Glass Front, Assembly Required, Rustic Brown
Collage Picture Frames, 4x6 Picture Frames Collage for Wall Decor, 10 Pack Photo Collage Frame for Gallery, Multi Family Picture Frame Set $24.99 Was $72.99

Now$2499
current price Now $24.99, Was $72.99$72.99
Collage Picture Frames, 4x6 Picture Frames Collage for Wall Decor, 10 Pack Photo Collage Frame for Gallery, Multi Family Picture Frame Set
44 out of 5 Stars. 4 reviews
Save with
Baseball and 4" X 6" Photo Vertical Display Case Plaque Cherry Finish Wood - Engraved $81.58

$8158
current price $81.58Baseball and 4" X 6" Photo Vertical Display Case Plaque Cherry Finish Wood - Engraved
Wall Decal : Horseshoe Western Star Picture Frame Cowboy Cowgirl Home Decor Living Room Bedroom 12x12 $18.55

$1855
current price $18.55Wall Decal : Horseshoe Western Star Picture Frame Cowboy Cowgirl Home Decor Living Room Bedroom 12x12
Baoblaze Desktop Acrylic Photo Album Clear Flip Display for Family Table Photo Display 6 inch photos Was $13.99

Baoblaze Desktop Acrylic Photo Album Clear Flip Display for Family Table Photo Display 6 inch photos
Set of 12 Collage Picture Frames, 4x6 for Wall Decor - Create a Stunning Family Gallery Display $27.99

$2799
current price $27.99Set of 12 Collage Picture Frames, 4x6 for Wall Decor - Create a Stunning Family Gallery Display
YLLSF Hollow 5cm photo frame three-dimensional hollow 67810 inch for A4 table, 6 inches

YLLSF Hollow 5cm photo frame three-dimensional hollow 67810 inch for A4 table, 6 inches
Hockey Puck and 8" X 10" Photo Horizontal Desktop Display Case - Cherry Finish Wood Base and Frame - Free Engraved Nameplate Plaque $79.99

$7999
current price $79.99Hockey Puck and 8" X 10" Photo Horizontal Desktop Display Case - Cherry Finish Wood Base and Frame - Free Engraved Nameplate Plaque
CTIRCHIU Desktop Picture Display Frame for Family Photos with Stylish Multicolor Design $9.46

$946
current price $9.46CTIRCHIU Desktop Picture Display Frame for Family Photos with Stylish Multicolor Design
Hollow 5Cm Photo Frame Three-Dimensional Hollow 67810 Inch For A4 Table A4 Smile Home

Hollow 5Cm Photo Frame Three-Dimensional Hollow 67810 Inch For A4 Table A4 Smile Home
Popular in Sample Picture
Related Products
Beautiful Haha Pretty City Denmark Desktop Display Photo Frame Picture Art Painting 5x7 inch
Beautiful Haha Pretty City Denmark Desktop Display Photo Frame Picture Art Painting 5x7 inch$25.99current price $25.99Black Cherry Ice Outline Desktop Display Photo Frame Picture Art Painting 5x7 inch
Black Cherry Ice Outline Desktop Display Photo Frame Picture Art Painting 5x7 inch$25.99current price $25.99Germany Cologne Cathedral Landmark Photo Frame Exhibition Display Art Desktop Painting
Germany Cologne Cathedral Landmark Photo Frame Exhibition Display Art Desktop Painting$22.99current price $22.99London England Flat Landmark Pattern Desktop Photo Frame Ornaments Picture Art Painting
London England Flat Landmark Pattern Desktop Photo Frame Ornaments Picture Art Painting$22.99current price $22.99London Tower Bridge Outline England Desktop Photo Frame Ornaments Picture Art Painting
London Tower Bridge Outline England Desktop Photo Frame Ornaments Picture Art Painting$22.99current price $22.99Fog Clouds Mountain Nature Travel Photo Frame Exhibition Display Art Desktop Painting
Fog Clouds Mountain Nature Travel Photo Frame Exhibition Display Art Desktop Painting$22.99current price $22.99Photograph Fresh Picture Nature Desktop Photo Frame Picture Art Decoration Painting 6x8 inch
Photograph Fresh Picture Nature Desktop Photo Frame Picture Art Decoration Painting 6x8 inch$22.99current price $22.99Graffiti Street Powerful AOE Explosion Desktop Wooden Photo Frame Display Picture Art Painting Multiple Sets
Graffiti Street Powerful AOE Explosion Desktop Wooden Photo Frame Display Picture Art Painting Multiple Sets$22.99current price $22.99Symmetrical Symbolic Reflection Urban Landscape Architecture Desktop Display Photo Frame Picture Art Painting 5x7 inch
Symmetrical Symbolic Reflection Urban Landscape Architecture Desktop Display Photo Frame Picture Art Painting 5x7 inch$25.99current price $25.99Print and frame your photograph art print
Print and frame your photograph art print$48.00current price $48.00Red White and Blue Picture Frame Wall Hanging USA Framing
Red White and Blue Picture Frame Wall Hanging USA Framing$61.00current price $61.00LINMOUA Large Framed Canvas Wood Frame Decorative Relax Calm Wood Frame for Canvas Oil Painting Nature DIY Frame Picture Inner Picture Frame
LINMOUA Large Framed Canvas Wood Frame Decorative Relax Calm Wood Frame for Canvas Oil Painting Nature DIY Frame Picture Inner Picture Frame$9.77current price $9.77Cafe Collage IV by Wild Apple Portfolio, Framed Wall Art, 13.25W x 13.25H
Cafe Collage IV by Wild Apple Portfolio, Framed Wall Art, 13.25W x 13.25H$49.99current price $49.99Jet Black Picture Frame, Photo Frame, Art Frame
Jet Black Picture Frame, Photo Frame, Art Frame$99.99current price $99.99Susannah Tucker Photography 12x12 Black Modern Framed Museum Art Print Titled - Budgie Photo Bomb
Susannah Tucker Photography 12x12 Black Modern Framed Museum Art Print Titled - Budgie Photo Bomb$29.99current price $29.99

































